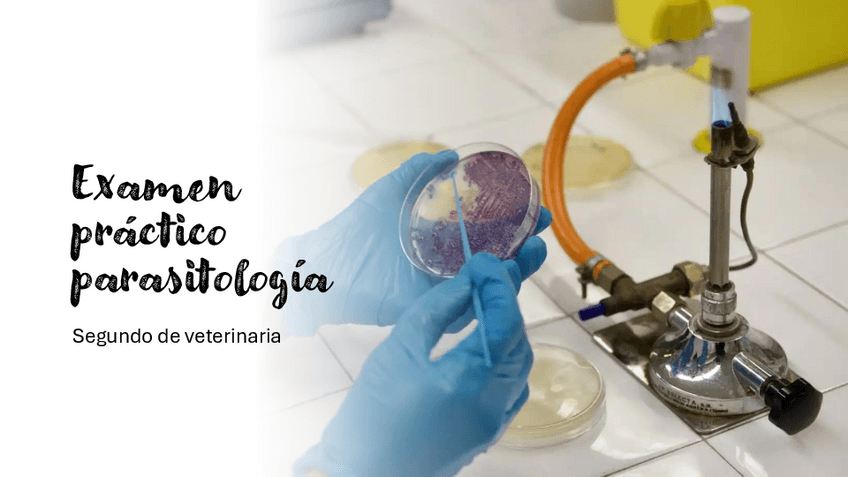

@vetalrescate16
351 Publicaciones
8.52k Interacciones
21 Seguidores
4 Siguiendo
Lista de publicaciones de vetalrescate16
He publicado nuevos apuntes de 2º Etnología y Etología: guia-identificacion-animal.pdf
He publicado nuevos apuntes de 2º Etnología y Etología: guia-de-zoometria.pdf
He publicado nuevos apuntes de 2º Parasitología: ejemplo-examen-practico.pdf
He publicado nuevos apuntes de 2º Parasitología: estudio-practico-parasitologia.pdf
apuntes
-
RESUMENES VIROLOGÍA
He publicado nuevos apuntes de 2º Microbiología e Inmunología: RESUMENES VIROLOGÍA
He publicado nuevos apuntes de 2º Bioestadística y Epidemiologia: tema-14-epi.pdf
He publicado nuevos apuntes de 2º Bioestadística y Epidemiologia: tema-13-epi.pdf
He publicado nuevos apuntes de 2º Microbiología e Inmunología: TEMA-49-VIROLOGIA.pdf
He publicado nuevos apuntes de 2º Microbiología e Inmunología: tema-47-virologia.pdf
He publicado nuevos apuntes de 2º Bioestadística y Epidemiologia: tema-12-epi.pdf
He publicado nuevos apuntes de 2º Microbiología e Inmunología: tema-46-virologia.pdf
He publicado nuevos apuntes de 2º Bioestadística y Epidemiologia: tema-11-epi.pdf
He publicado nuevos apuntes de 2º Microbiología e Inmunología: tema-45-virologia.pdf
He publicado nuevos apuntes de 2º Parasitología: TEMA-4-PROTISTAS-PARASITOS.pdf